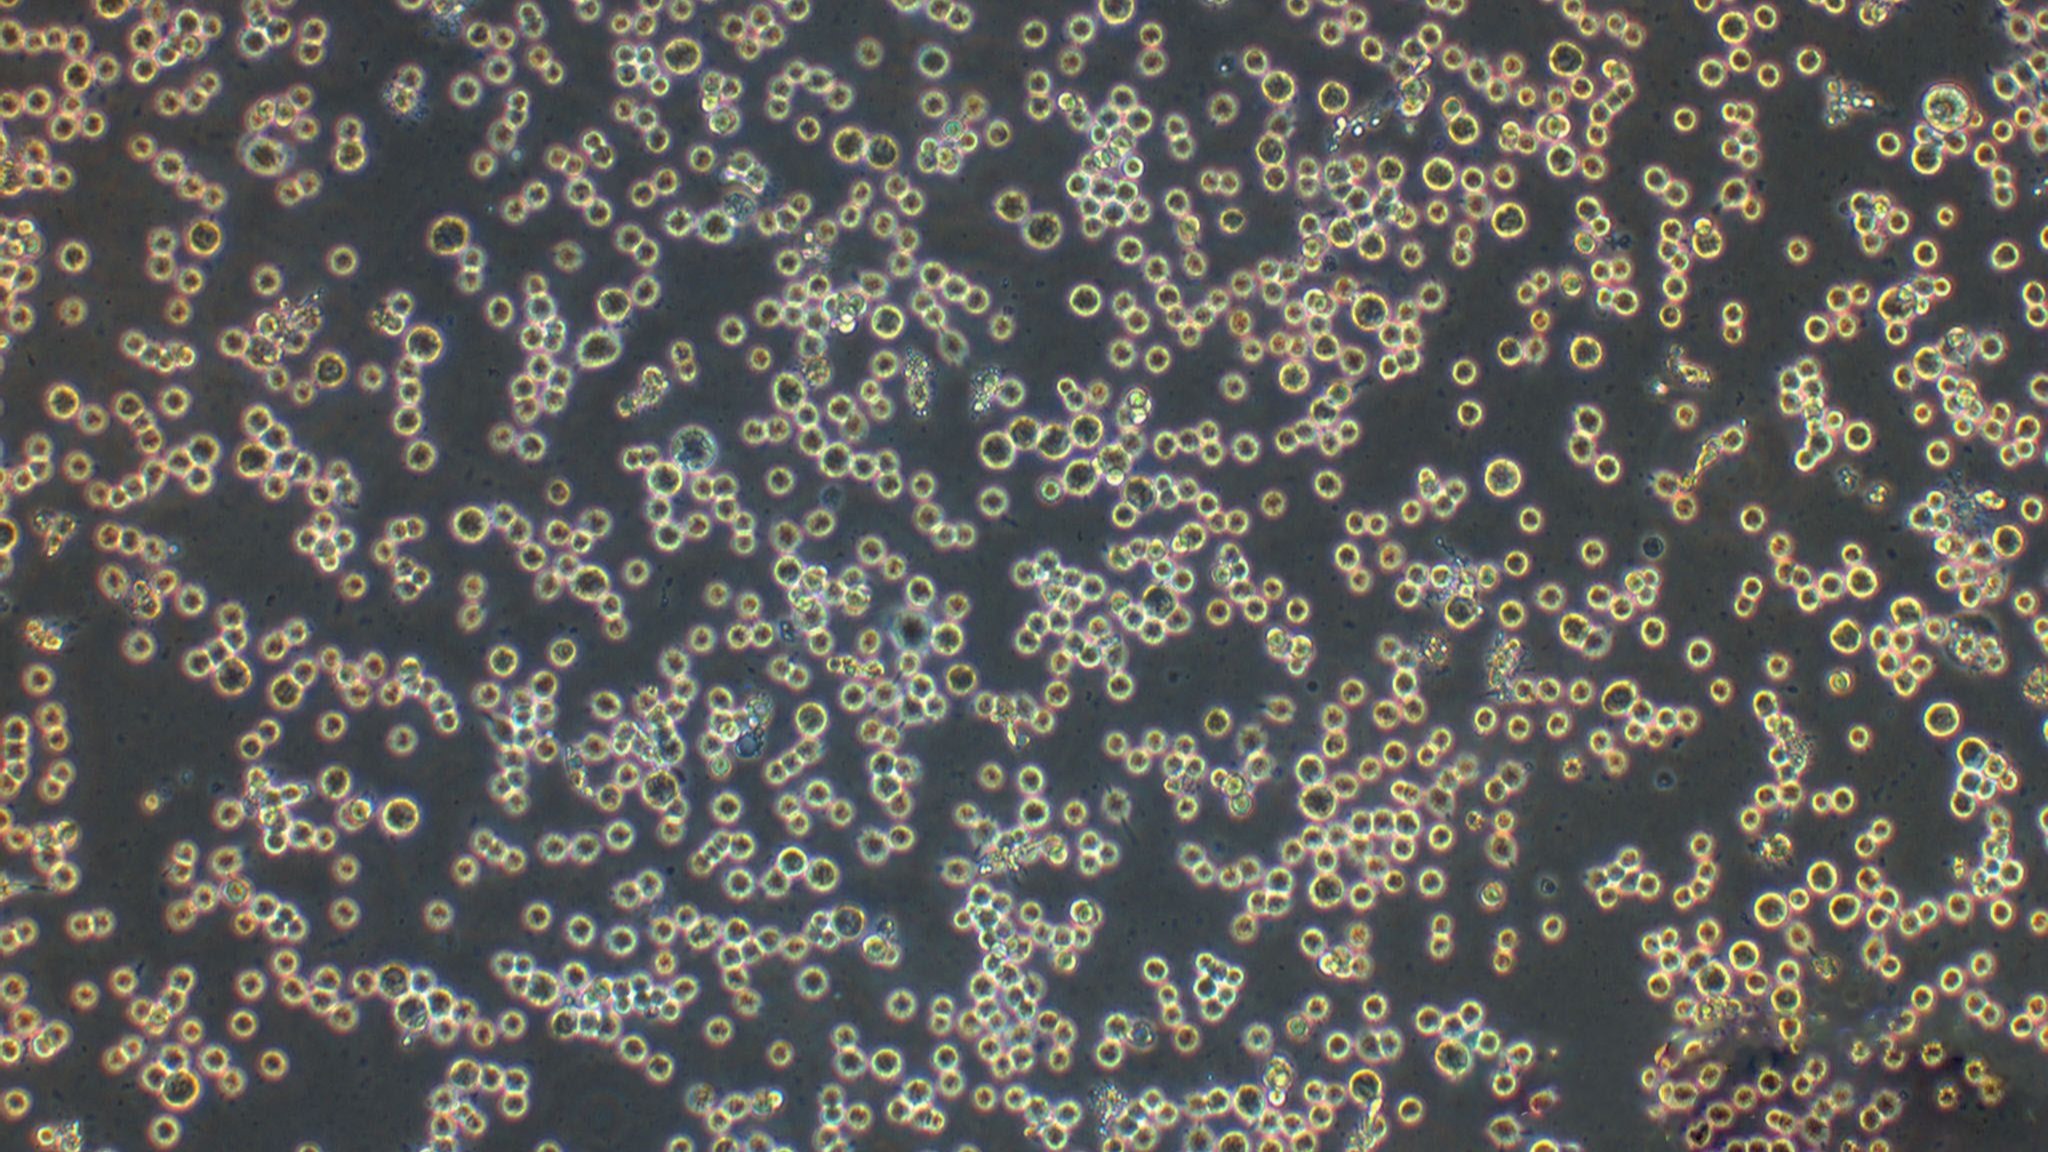
pbmc细胞,pbmc细胞冻存液 pbmc细胞,pbmc细胞冻存液

>
外周血单个核细胞PBMC攻略一PBMC概述 外周血单个核细胞Peripheral Blood Mononuclear Cellspbmc细胞,PBMC是外周血中具有单个核的细胞的混合细胞群体pbmc细胞,主要包括自然杀伤细胞NKT淋巴细胞占比70%90%B淋巴细胞等这些细胞能够进一步分离纯化,是免疫细胞的主要来源,广泛应用于免疫学恶性肿瘤;外周血单个核细胞PBMC是由淋巴细胞T细胞B细胞和NK细胞和单核细胞组成的一类细胞以下是关于外周血单个核细胞PBMC的详细介绍定义与组成外周血单个核细胞Peripheral Blood Mononuclear Cell,PBMC是外周血中具有单个核的细胞,属于白细胞WBC的一个子集PBMC主要由淋巴细胞包括。
单核细胞单核细胞是PBMC中的另一主要细胞类型它们是免疫系统中的重要组成部分,参与机体的防御反应,如吞噬病原体和细胞碎片等PBMC还包括其他细胞类型,如树突状细胞自然杀伤细胞等这些细胞在免疫系统中各有其特定的功能,共同维护机体的健康例如,树突状细胞在抗原识别和信息传递方面发挥关键;PBMC由血液中单核细胞淋巴细胞T细胞B细胞和自然杀伤细胞以及吞噬细胞和树突状细胞组成,它们共同构成免疫系统的前线防线淋巴细胞作为先天和适应性免疫的核心,抵挡病毒细菌寄生虫侵袭,并能识别并消除肿瘤细胞,确保身体的健康防护二分离PBMC的科学智慧 分离PBMC的关键在于精细操控,通常采用F。
1、PBMC外周血单个核细胞主要包括淋巴细胞T细胞B细胞和NK细胞和单核细胞,是研究免疫应答和疾病机制的重要细胞群体二PBMC制备 制备原理 PBMC的制备通常基于密度梯度离心法,利用Ficoll等密度梯度介质将不同密度的细胞分离开来密度梯度离心workflow 步骤采集外周血样本后,使用抗凝剂处理,然后缓。
2、2 免疫功能 这些细胞在体内的免疫防御和免疫调节中起着至关重要的作用,参与对抗病原体清除衰老或异常细胞等过程3 医学应用 外周血PBMC作为免疫反应的有效指标,广泛应用于疾病的诊断预后以及治疗 在肿瘤学领域,PBMC可以为肿瘤的诊断疾病分期提供重要信息 在感染病学领域,PBMC有助于。
3、外周血单个核细胞是指存在于人体外周血中具有单个核结构的细胞群体它主要包含以下几种细胞类型淋巴细胞是免疫系统中的重要组成部分,负责识别和攻击病原体,如病毒细菌等,同时也在维护免疫平衡方面发挥重要作用单核细胞也被称为巨噬细胞的前体,它们在炎症反应中起着关键作用,能够吞噬并分解病原体和坏死细胞,从而帮助。
4、PBMC常用于免疫原性测定细胞标志物研究细胞治疗研究等领域通过特定的分离技术,如密度梯度离心法,可以从外周血中分离出PBMC此外,PBMC的保存和运输通常采用冷冻保存的方式,以确保细胞的活性和稳定性二人骨髓单个核细胞BMNCBMNC是从捐赠者骨髓中分离出来的具有单个核的细胞混合群体,这些细胞。
5、组成淋巴细胞占PBMC的70%90%,是PBMC中数量最多的细胞类型淋巴细胞主要包括T细胞B细胞和NK细胞其中,T细胞占4570%,负责细胞免疫应答B细胞占515%,负责体液免疫应答NK细胞占510%,具有直接杀伤靶细胞的能力,无需预先致敏单核细胞占PBMC的1030%,是PBMC中的另一种重要细胞。
6、1 PBMC是外周血中具有单个核结构的细胞群体的总称2 这些细胞主要包括淋巴细胞单核细胞和树突状细胞等3 淋巴细胞在免疫系统中扮演关键角色,能识别并攻击病原体,维护免疫平衡4 单核细胞,或称为巨噬细胞,在炎症反应中具有重要作用,能吞噬并分解病原体和坏死细胞5 树突状细胞作为。
7、PBMC,即外周血单个核细胞,是血液中具有单个核的细胞的总称,主要包括淋巴细胞TB单核细胞吞噬细胞树突状细胞和其他少量细胞类型其中,淋巴细胞占据很大比例分离PBMC的主要目的是去除多核细胞和红细胞,以便在体外模拟血液免疫环境进行研究二工具与原料 全血以10ml为例无菌PBS溶液。
8、通过流式细胞术进行PBMC免疫表型分析 流式细胞术是一种强大的技术,广泛应用于PBMC外周血单核细胞的免疫表型分析该技术通过测量细胞表面分子的表达,即“分化簇”CD标记,来识别区分和表征PBMC亚群以下是进行PBMC免疫表型分析的详细步骤一PBMC的制备 PBMCs通常通过密度梯度离心或磁珠分离从。

9、外周血PBMC是指外周血单个核细胞,它是指血液中除去红细胞白细胞细胞外的淋巴细胞单核细胞及相关的前体细胞的混合物这些细胞在体内的免疫防御和免疫调节中起着至关重要的作用,因此对外周血PBMC的研究有助于深入pbmc细胞了解人体免疫系统的运行机制外周血PBMC作为免疫反应的有效指标,广泛应用于疾病的诊断预后以及治疗例如,在肿瘤学。
10、PBMC 或全血,应该选哪个取决于pbmc细胞你的研究目的如果研究目的是检测红细胞或血小板选择全血因为全血中包含pbmc细胞了红细胞和血小板,这些细胞对于研究这些特定类型的细胞至关重要如果研究目的是检测粒细胞虽然全血中包含粒细胞,但可以通过裂解红细胞来简化样本处理,因为红细胞在全血中占比极高,且对抗体标记。
11、PBMC 或全血,应该选哪个取决于研究目的如果研究目的是检测红细胞或血小板应该选择全血因为全血中包含了红细胞和血小板,这些细胞对于研究这些特定类型的细胞至关重要如果研究目的是检测粒细胞虽然全血中包含粒细胞,但通常可以通过裂解红细胞来更准确地检测粒细胞裂解红细胞可以减少红细胞对抗体标记。
1、PBMC细胞提取操作步骤如下一准备材料 人全血15ml离心管DPBSDulbecco#39s Phosphate Buffered Saline,杜氏磷酸盐缓冲液PBMC细胞分离液如启达生物,catlogSD0060PBMC无血清细胞培养基如启达生物,CatlogP1901二PBMC细胞提取步骤 稀释全血将10ml全血转入50ml离心管中,加入10ml PBS溶液。
2、Ficoll密度梯度离心法是一种常用的分离外周血单个核细胞PBMC的方法其原理基于不同细胞在Ficoll溶液中的沉降系数不同,从而实现细胞的分离Ficoll是蔗糖的多聚体,呈中性,平均分子量为400,000,当密度为12gmL时,既不会超出正常生理性渗透压,也不会穿过生物膜在离心过程中,由于红细胞和粒。
3、树突状细胞这些细胞是免疫系统中的专业“哨兵”,它们能够识别并呈递抗原给淋巴细胞,启动免疫应答还有少量的其他细胞,如造血干细胞,它们具有分化为各种血细胞的潜能,是血液和免疫系统再生的关键总体来说,PBMC在人体免疫反应和血液系统的正常功能中发挥着至关重要的作用通过研究PBMC,科学家可以。
相关标签 :
上一篇: 30秒偷走特斯拉,特斯拉被偷了怎么办
下一篇: 网络硬件知识,网络硬件基础知识
微信医疗(登记+咨询+回访)预约管理系统
云约CRM微信小程序APP系统定制开发
云约CRM体检自定义出号预约管理系统
云约CRM云诊所系统,云门诊,医疗预约音视频在线问诊预约系统
云约CRM新版美容微信预约系统门店版_门店预约管理系统
云约CRM最新ThinkPHP6通用行业的预约小程序(诊所挂号)系统联系电话:18300931024
在线QQ客服:616139763
官方微信:18300931024
官方邮箱: 616139763@qq.com